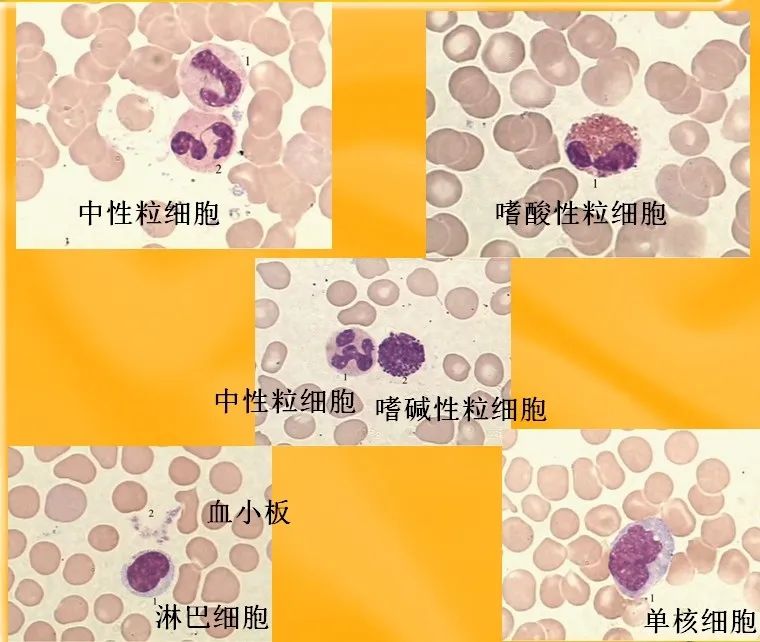
化疗期间补硒吃什么（化疗时补硒可以减轻副作用吗）-硒宝网

化疗期间补硒吃什么(化疗时补硒可以减轻副作用吗)
(1)、硒联合化疗

对于硒联合化疗治疗肺癌带来的相关副作用,人们也进行了研究。Hu等(1997)将41例患者随机分为AB两组,其中A组为20例,第1个疗程化疗期间补硒,以第2个疗程化疗不补硒作为对照;B组则与其相反,21例患者第1个疗程期间补硒作为对照。经研究发现,在化疗第14天,补硒组外周血白细胞计数明显高于对照组,另外发现,补硒组粒细胞集落刺激因子的消耗明显低于对照组,输血量也低于对照组。由此可见,对于血清硒水平较低的肺患者,补硒可以减轻顺铂治疗所导致的骨髓抑制和肾中毒。
(2)、硒联合化疗

MIX等(2015)为了确定口服L-硒代蛋氨酸(SLM)联合化疗(CCRT)同步治疗三期非小细胞肺癌(NSCLC)的安全性和耐受性,并估计其使用是否可以降低不良事件的发生率和严重程度。选择16名3期NSCLC患者参与了这项单臂临床2期研究。CCRT包括辐射计量为2Gy/次,30-33次,每周5d,患者未接受诱导化疗。同步化疗包括紫衫醇静脉注射超过1h,然后卡铂在血浆浓度-时间曲线下的某个区域,静脉注射超过30min。这些药物每周在胸腔放疗前30分钟静脉注射一次,从放疗第1天开始,持续6周。根据机构标准,患者接受了预先药物和止吐药物。允许使用促红细胞生成素。粒细胞集落刺激因子的使用是不鼓励的,并且不允许作为预防,或旨在防止特定方案治疗的延迟。SLM800Чg胶囊的剂量如下,总计共7周;患者在开始CCRT之前接受负荷剂量SLM4800Чg口服,每天2次,持续一周,之后维持剂量为每天4800Чg,持续6周或知道治疗完成。这种负荷给药计划是基于药动力学模型,旨在开始CCRT之前达到接近预约的稳定浓度的血清水平,每天延长给药4800Чg。结果未观察到硒相关毒性。16例中3级以上食管炎3例(19%),肺炎0例,白细胞减少2例(12.5%),贫血1例(6%);与方案规定的35预期率相比,后两者显著降低。总生存率中位数为14.9个月,无生败生存率中位数为9个月。结论:对于不能手术的NSCLC,在CCRT的设置中,硒可能有一定的?;ぷ饔?。数据表明,与相似治疗历史和当代对比相比,骨髓抑制的发生率降低。

继续阅读
- 暂无推荐
